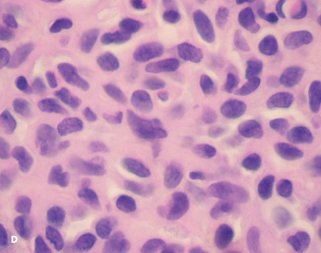
Glomus Tumor

Glomus Tumor of the Breast
 A 49-year-old woman presented for evaluation of spontaneous bloody discharge from her nipple of 2 weeks’ duration. She was also able to express the discharge and had some associated breast soreness. Results of yearly screening mammograms had all been normal.
A 49-year-old woman presented for evaluation of spontaneous bloody discharge from her nipple of 2 weeks’ duration. She was also able to express the discharge and had some associated breast soreness. Results of yearly screening mammograms had all been normal.
Examination of the breasts and axillae was normal, except for expression of scant bloody nipple discharge. Testing of the nipple discharge for occult blood was positive. Culture was obtained, which was sterile; the discharge was sent on a glass slide for microscopic examination, which was nondiagnostic.
A diagnostic mammogram and an ultrasound scan were normal. An MRI scan of the breast revealed an abnormally enhancing 1-cm lesion within the right upper-inner quadrant (A and B). MRI-guided needle biopsy was performed; pathology results demonstrated a glomus tumor (C and D).
Glomus tumors are rare. They result from hyperplasia of any of the components of a glomus body, which is a contractile neuromyoarterial receptor originating from modified smooth muscle that helps control blood pressure and temperature by regulating peripheral blood flow through arteriovenous shunting.1 The tumors can arise from
any normal glomus body and most commonly occur subungually, but they have been found in all systems and in all regions of the body, including sites where normal glomus bodies do not exist.
The first account of a glomus tumor of the breast was described in 2009 by Yalcin and colleagues.2 The next year, a report of a 25-year-old man with a painful, 1-cm breast nodule found to be a glomus tumor was published.3
Clinically, glomus tumors most often present as solitary, less than 1 cm masses associated with easily pinpointed pain and localized tenderness. They may also be accompanied by color change and hypersensitivity to cold. Multiple, often asymptomatic, lesions also exist.

Diagnostic enhanced contrast MRI (DCMRI) as well as ductoscopy are often useful in the workup of pathologic nipple discharge. DCMRI can help determine whether a lesion is malignant.
Nipple discharge is the third most common patient complaint related to the breast.4 The presence of blood, and spontaneity, are clinical features most often associated with nipple discharge that is pathologic, while the co-occurrence of a palpable mass is the feature most associated with malignancy.5 Cytologic evaluation has not proved to be of benefit, nor has occult blood testing, because the absence of blood is not helpful to rule out malignancy.6,7

Glomus tumors are typically benign; however, there is also the possibility of a glomus tumor with uncertain malignant potential, or a malignant glomus tumor (glomangiosarcoma). Malignant transformation of a previously benign appearing tumor has also been described but is exceedingly rare.8 The criteria for malignancy include size larger than 2 cm, as well as specific cytologic features.
Treatment is surgical and in most cases requires an operating microscope. Surgical duct excision is the gold standard for treatment.1,5 Benign, asymptomatic tumors may not necessarily require resection; this patient opted to avoid surgery and has had no further related complaints in the interim period of nearly 2 years.
Acknowledgment: The authors would like to thank Douglas M. Hughes, MD, for his assistance in preparing photomicrographs of the pathology specimens.
Acknowledgment: The authors would like to thank Douglas M. Hughes, MD, for his assistance in preparing photomicrographs of the pathology specimens.
1. Nazerani S, Motamedi M, Keramati M. Diagnosis and management of glomus tumors of the hand. Tech Hand Up Extrem Surg. 2010;14(1):8-13.
2. Yalcin S, Ergul E, Ucar A, Ulger B, Korukluoglu B. Glomus tumor of the breast: first report. Langenbeck’s Arch Surg. 2009;394(2):399-400.
3. Mehdi G, Siddiqui F, Ansari H, Mansoor T. Glomus tumor occuring in male breast—an unusual site of presentation. J Postgrad Med. 2010;56(3):218-219.
4. Choudhury S, Isomoto I, Hyashi K. Magnetic resonance imaging features of breasts in patients with nipple discharge. Bangladesh Med Res Counc Bull. 2008;34(2):44-47.
5. Morrogh M, Park A, Elkin E, King T. Lessons learned from 416 cases of nipple discharge of the breast. Am J Surg. 2010;200(1):73-80.
6. Fisher C, Margenthaler J. A look into the ductoscope: its role in pathologic nipple discharge. Ann Surg Oncol. 2011;18(11):3187-3191.
7. Frank J, Lynch K, Barrows G. Nipple smear cytology is of no value in the management of women with nipple discharge. Conn Med. 2010;74(4):207-210.
8. De Chiara A, Apice G, Ninfo V, et al. Malignant glomus tumour: a case report and review of the literature. Sarcoma. 2003;7(2):87-91.


